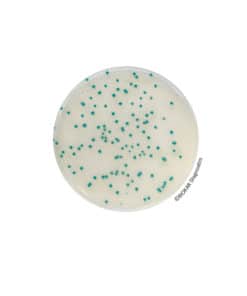
RHAPSODY Agar® - Pre-poured medium  BM16708 | Medical Supply Company
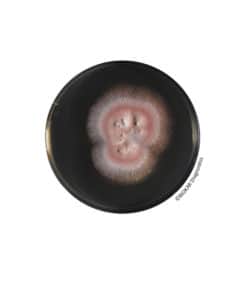
Sabouraud  Dextrose Agar (SDA) - Pre-poured medium BM17308 | Medical Supply Company

Ready-To-Use media
Ready-To-Use media
Ready-To-Use media
Ready-To-Use media
Ready-To-Use media
Ready-To-Use media
Ready-To-Use media
RAPPAPORT-VASSILIADIS Soja (RVS) Broth – Ready-to-use medium
Ready-To-Use media
Ready-To-Use media
Ready-To-Use media
Ready-To-Use media
Sabouraud Dextrose Chloramphenicol Agar (SDCA) – Ready-to-melt medium
Ready-To-Use media
Sabouraud Dextrose Chloramphenicol Agar (SDCA) – Ready-to-melt medium